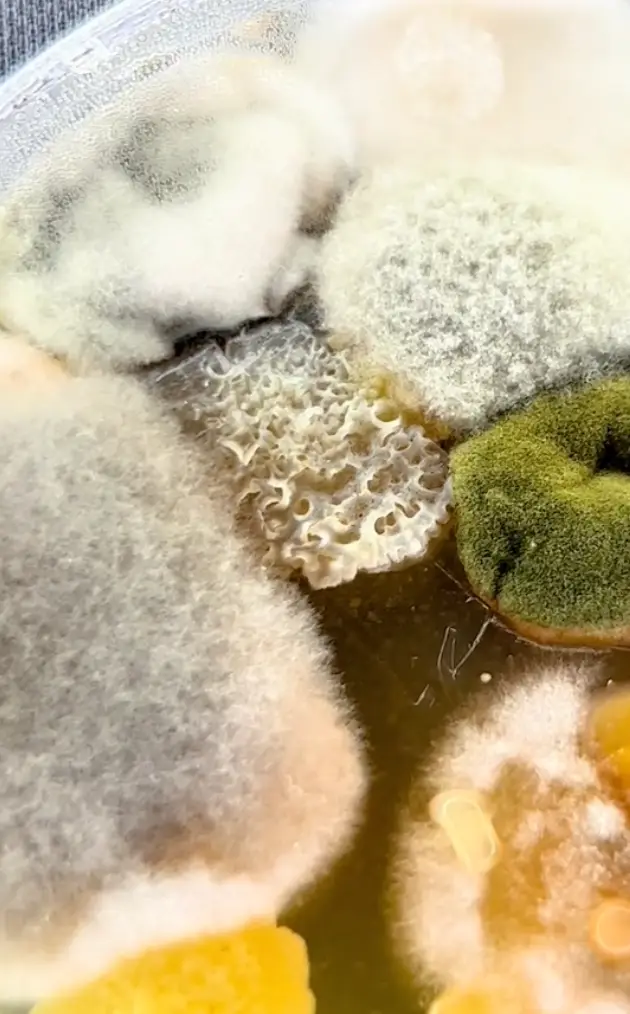
The floor popcorn was filled with bacteria and fungus.

A microbiologist has made an eery discovery about cinema popcorn - and it'll make you think twice about when you eat the snack, that's for sure.
Tim, who runs TikTok account @whatmightgrow, explained how he wanted to conduct an experiment about popcorn sold in cinemas.

For most of us, popcorn is the number one choice at the cinema, alongside the likes of pick n mix, nachos and of course, all the overpriced bags of chocolate.
Advert
But what Tim discovered about the snack - and cinemas in general - is pretty gross.
In fact, it'll make you completely re-think the 'five-second rule'.
In the clip, Tim collected fresh popcorn from the paper bag and popcorn that had fallen on the floor during the film.
He took it back to the lab, and placed samples from each container into a petri dish, before popping in the incubator.
The results were pretty astounding.
Tim found that the popcorn that had been on the floor was covered in bacteria and fungus.
Meanwhile, the 'fresh' popcorn had a small amount of bacteria, which Tim guessed would be Staphylococcus, which is commonly found on humans.
Tim explained: "In this fun experiment, I went to a movie theater and tested the popcorn they sold.
"Additionally, for comparison, I grabbed some popcorn off the floor to show that bacteria can grow on popcorn. Unsuprisingly, popcorn from the floor is filthy."
Tim explained that when he worked as a microbiologist, he would commonly test items that had been on the floor.
"EVERY SINGLE TIME I would find some of the craziest growths and via PCR it was determined to almost always have pathogens present. The most common pathogen I would see were Staphylococcus, Listeria, E. Coli, and Salmonella," he added.
So next time you drop food on the floor and apply the five-second rule, you might want to think again.
"The lesson of this mini experiment is to show what you would find if you were to eat things off the floor," Tim added.
"I wish I knew this as a little kid, because I was notorious for going to the candy section where you could scoop out candy into bags, and eating any candy that was on the floor."
People were pretty horrified in the comments, with one person writing: "Moral of the story: don't eat floor popcorn!"
While another said: "This is why there is no such thing as a 5 second rule."
This has seriously made us re-think our habits.